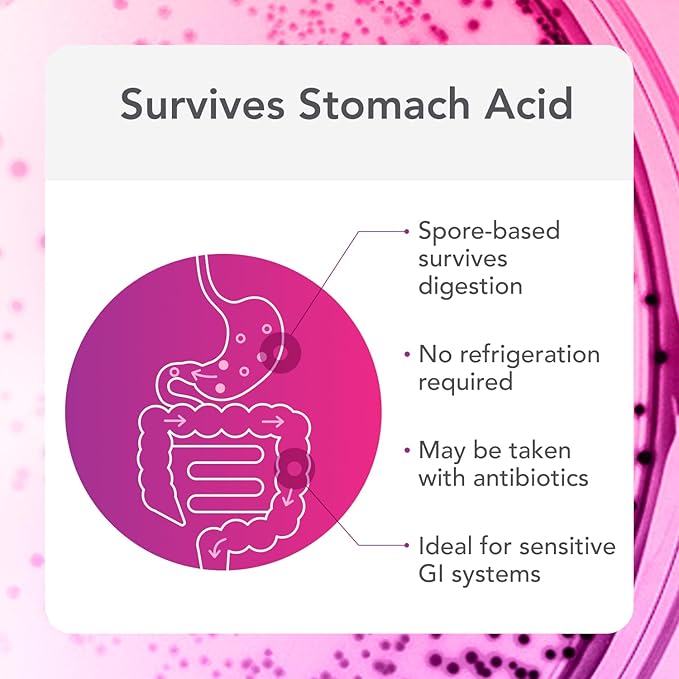

Bio-BotanicalResearch
Biocidin Proflora 4R Spore Probiotic - Digestive Health Probiotics for Women & Men - Clinically Researched Bacillus Strains & Organic Aloe, Marshmallow Root for Gut Support (30 Vegan Capsules)
Biocidin Proflora 4R Spore Probiotic - Digestive Health Probiotics for Women & Men - Clinically Researched Bacillus Strains & Organic Aloe, Marshmallow Root for Gut Support (30 Vegan Capsules)
픽업 사용 가능 여부를 로드할 수 없습니다.
About This
- Clinically Researched Spore-Based Probiotics – Features a potent blend of three Bacillus probiotics for digestive health. These species can help promote nutrient absorption and microbial balance in the gut. With our improved formulation, we've increased potency by 33% to 4 billion CFUs.*
- Promote Digestive Balance & Comfort - We designed these probiotics for women and men who want to maintain a healthy gut barrier, and support microbial diversity in the GI tract. They can also help manage occasional bloating, gas and indigestion while promoting regularity and normal bowel movements.*
- With Soothing Botancials - This daily probiotic supplement combines soil-based, spore-forming probiotics with Marshmallow Root, Aloe Vera, and Quercetin to help calm your gut lining.*
- Shelf-Stable - These women's and men's probiotic capsules do not require refrigeration and can survive through the GI tract.
- Pair with Biocidin or GI Detox Binder - A great stand-alone spore probiotic, and a perfect addition to Biocidin GI detox and gut cleanse protocols. Probiotics for men and women with professional grade ingredients.*
Overview
- Brand : Bio-Botanical Research
- Flavor : Marshmallow
- Primary Supplement Type : Probiotic & Botanicals
- Unit Count : 30 Count
- Item Form : Capsule
- Diet Type : Gluten Free, Vegan, Vegetarian
- Product Benefits : Digestive Health Support, Gut Health Support
- Age Range (Description) : Adult
- Package Information : Bottle
- Number of Items : 1
Share









QNA
How can I request a return or refund?
A. We accept returns within 30 days of delivery if the item is unused, in original packaging, and with proof of purchase. Please email us at ellozz0708@gmail.com to request a return. Return labels and instructions will be provided. Note: Custom items, food, sale items, and gift cards are non-refundable.
Q. How long does shipping take?
A. USA orders arrive in 3–8 business days after processing. International orders take 3–12 business days. Customs delays are beyond our control.
Q. Can I cancel my order?
A. Cancellations are possible within 30 minutes after placing your order. A $20 cancellation fee applies per order. Once processed, cancellations are not possible.
Q. Do you provide tracking?
A. Yes! Tracking details will be emailed as soon as your package ships. Please check your email for updates.
Q. What if my delivery is delayed?
A. Rare delays may occur. If no tracking updates appear for 30–60 business days, we’ll reship your order free of charge.
📦 SHIPPING POLICY
📦 SHIPPING DETAILS
Processing Time: 3–5 business days
Shipping Time:
• USA: 3–8 business days
• Rest of World: 3–12 business days
Tracking: Sent to your email once your order ships.
Important Note:
Customs delays or peak seasons may affect delivery times. If no tracking updates appear after 30–60 business days, a replacement will be sent.
Shipping Fee: Varies by region. Free shipping available during select promotions.
For any questions, please contact us:
📧 ellozz0708@gmail.com